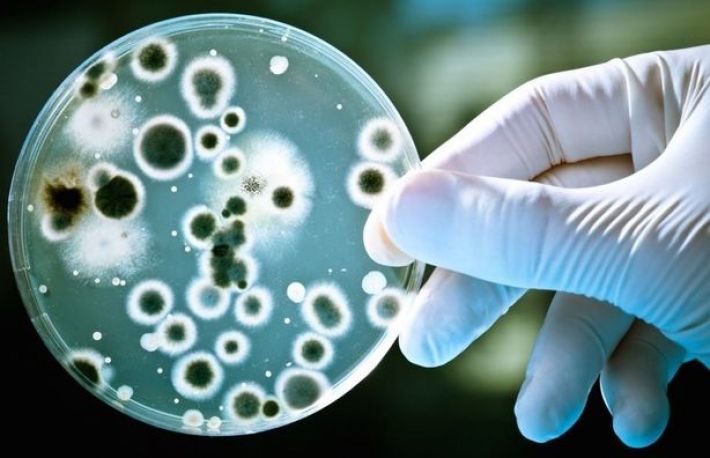

Candidoza este o infectie a mucoaselor si a pielii provocata de ciuperci din genul Candida. Majoritatea femeilor sunt afectate, cel putin o data in viata, de candidoza vaginala.
Mancarimile vaginale, usturimile sau scurgerile albicioase dense pot fi provocate de ciuperca denumita Candida albicans. Aceasta infectie e favoritaza, de multe ori, de tratamentele indelungate cu antibiotice care afecteaza flora bacteriana a colonului sau de anticonceptionale. Ciuperca se poate transmite prin contact sexual.
Tratament medical:
Au existat modificari in tratamentul candidozei in ultimii ani, insa fluconazolul (antifungic) este considerat, in continuare, un agent de prima intentie la persoanele cu candidoza repetata sau invaziva.
Tratamente naturale:
1. Spalaturile vaginale cu infuzie concentrata de rozmarin, cimbru si salvie reprezinta un remediu eficient impotriva candidozei.
2. Apa sarata. Pune un pumn de sare de mare in apa de baie. Combinatia va calma mancarimile produse de ciuperca si va grabi vindecarea.
3. Prin stimularea imunitatii, echinaceea ajuta in procesul de vindecare a infectiei. Se recomanda ceai, capsule sau tinctura, administrate zilnic, timp de 3-4 saptamani.
4. Usturoiul consumat zilnic lupta impotriva candidozei. Are proprietati antifungice si antibacteriene.
5. Pelinul. Fa spalaturi vaginale zilnice cu infuzie combinata de pelin (infuzie obisnuita + macerat la rece, in cantitati egale), in tratamente de cate o saptamana, cu o saptamana de pauza.
Pelinul este un puternic antiinfectios si antiinflamator.
6. Scortisoara are proprietati antifungice. Fierbe intr-un litru de apa, timp de 5 minute, 2 batoane de scortisoara, rupte bucatele. Lasa o ora in aceeasi apa, strecoara si fa apoi spalaturi vaginale sau se bea acest decoct.
Sfaturi de prevenire:
- usuca-te bine dupa baie, mai ales in zona intima;
- nu folosi sapun in jurul vaginului. Acesta omoara bacteriile bune si nu are niciun efect asupra Candidei;
- sterge-te din fata spre spate, dupa ce folosesti toaleta. Zona rectala este plina de bacterii;
- evita chilotii tanga si lenjeria intima prea stramta;
- asigura-te ca partenerul nu este infectat.

Dacă ți-a fost util,
trimite mai departe